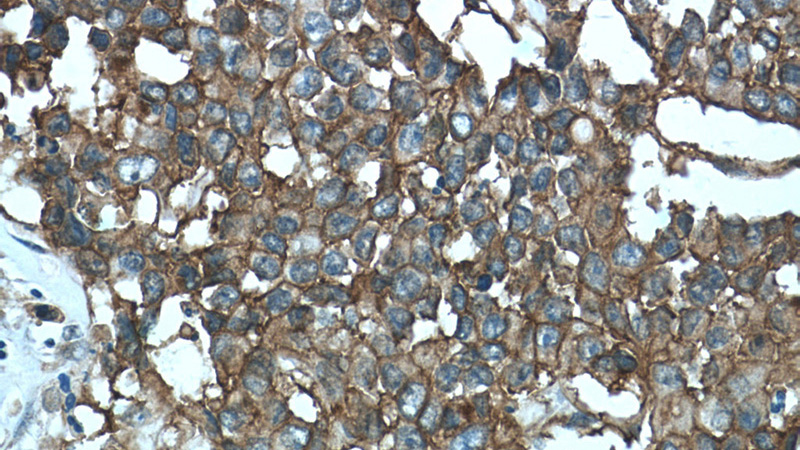
Immunohistochemistry of paraffin-embedded human colon cancer tissue slide using Catalog No:107144(CD9 Antibody) at dilution of 1:50 (under 40x lens)

-
Product Name
CD9 antibody
- Documents
-
Description
CD9 Mouse Monoclonal antibody. Positive WB detected in Hela cells. Positive IHC detected in human colon cancer tissue. Observed molecular weight by Western-blot: 25 kDa
-
Tested applications
ELISA, WB, IHC
-
Species reactivity
Human,Mouse; other species not tested.
-
Alternative names
5H9 antibody; 5H9 antigen antibody; BA2 antibody; BTCC 1 antibody; CD9 antibody; CD9 antigen antibody; CD9 molecule antibody; DRAP 27 antibody; GIG2 antibody; LeukOCyte antigen MIC3 antibody; MIC3 antibody; Motility related protein antibody; MRP 1 antibody; P24 antibody; Tetraspanin 29 antibody; Tspan 29 antibody; TSPAN29 antibody
-
Isotype
Mouse IgG1
-
Preparation
This antibody was obtained by immunization of CD9 recombinant protein (Accession Number: NM_001769). Purification method: Protein G purified.
-
Clonality
Monoclonal
-
Formulation
PBS with 0.02% sodium azide and 50% glycerol pH 7.3.
-
Storage instructions
Store at -20℃. DO NOT ALIQUOT
-
Applications
Recommended Dilution:
WB: 1:500-1:5000
IHC: 1:20-1:200
-
Validations

HeLa cells were subjected to SDS PAGE followed by western blot with Catalog No:107144(CD9 antibody) at dilution of 1:1000

Immunohistochemistry of paraffin-embedded human colon cancer tissue slide using Catalog No:107144(CD9 Antibody) at dilution of 1:50 (under 10x lens)
Immunohistochemistry of paraffin-embedded human colon cancer tissue slide using Catalog No:107144(CD9 Antibody) at dilution of 1:50 (under 40x lens)
-
Background
The cell-surface molecule CD9, a member of the transmembrane-4 superfamily, interacts with the integrin family and other membrane proteins, and is postulated to participate in cell migration and adhesion. Expression of CD9 enhances membrane fusion between muscle cells and promotes viral infection in some cells (PMID:10459022). It is often used as a mesenchymal stem cell marker (PMID:18005405). CD9 is also known as the p24 antigen besides MIC3, TSPAN29 because it is a protein of molecular weight 24 kD. The CD9 antigen appears to be a 227-amino acid molecule with 4 hydrophobic domains and 1 N-glycosylation site.
Related Products / Services
Please note: All products are "FOR RESEARCH USE ONLY AND ARE NOT INTENDED FOR DIAGNOSTIC OR THERAPEUTIC USE"
